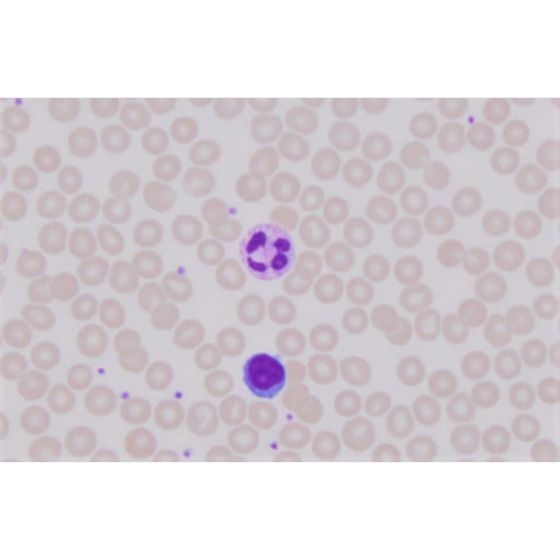
Giemsa 500 ml Merck

Eosina-Blu di Metilene Sec. May-Grünwald 500 ml (1.01424.0500) Sigma-Aldrich
Eosina-Blu di Metilene Sec. May-Grünwald 500 ml Sigma-Aldrich
52,20 €
Le immagini del prodotto sono puramente indicative.
Prezzo esposto da ritenersi IVA esclusa.
Il prezzo indicato potrebbe non essere aggiornato con gli attuali listini in vigore.
Richiedi un preventivo per conoscere la quotazione esatta di listino.
Descrizione
Per ulteriori dettagli tecnici clicca qui
Il metodo di colorazione secondo May-Grünwald costituisce una delle tecniche standard nelle procedure diagnostiche ematologiche.
Analogamente all'eosina-blu di metilene di Wright e all'eosina-blu di metilene di Leishman, questa soluzione pronta all'uso viene utilizzata per la colorazione di strisci di sangue e midollo osseo e per quella di campioni citologici clinici.
Il flacone da 500 mL assicura circa 1.500 colorazioni.
La soluzione di May-Grünwald all'eosina-blu di metilene è un prodotto registrato come IVD e certificato CE; 500 mL sono sufficienti per colorare fino a 1.600 vetrini in vaschette di Hellendahl.
Per maggiori dettagli, si prega di consultare le istruzioni per l'uso (IFU) che possono essere scaricate da questa pagina internet.
Risultati analitici
– Idoneità per microscopia (striscio di sangue): conforme
– Eritrociti:da rosa a brunastro
– Nuclei: viola
– Granuli eosinofili: rosso-marrone
– Granuli neutrofili: viola chiaro
– Citoplasma dei linfociti:blu
Dettagli del prodotto
| Confezione | |
|---|---|
| Soluzione | |
| Prodotto padre | 13.1560.79 |